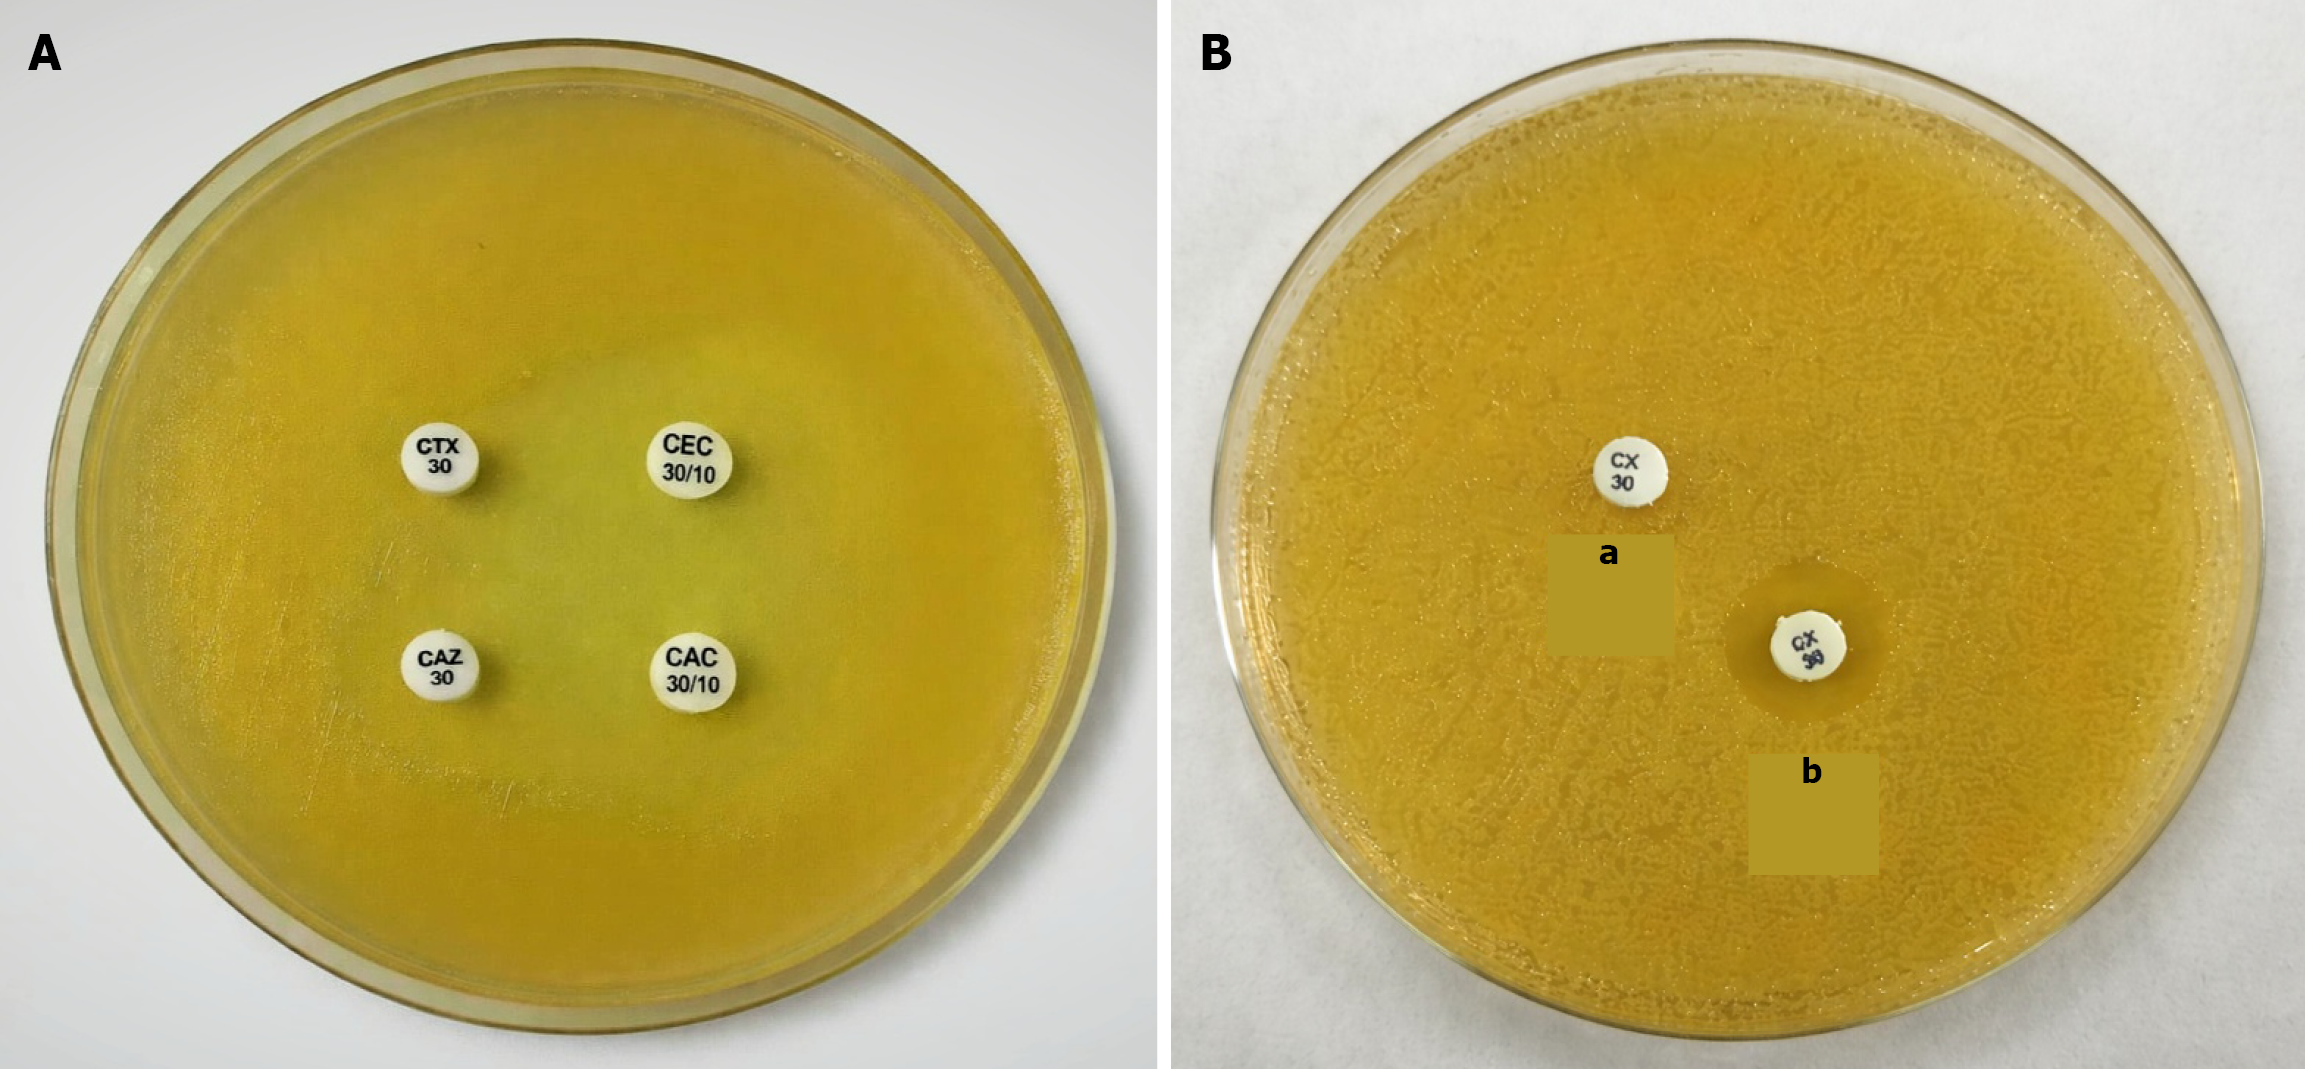

Copyright: ©Author(s) 2026.
World J Virol. Mar 25, 2026; 15(1): 118602
Published online Mar 25, 2026. doi: 10.5501/wjv.v15.i1.118602
Published online Mar 25, 2026. doi: 10.5501/wjv.v15.i1.118602
Figure 1 Phenotypic methods for detection of beta-lactamases.
A: Extended-spectrum beta-lactamases detection by combined disc diffusion test; B: Detection of AmpC by boric acid and ethylenediamine tetraacetic acid (a: Cefoxitin, b: Cefoxitin with boric acid and ethylenediamine tetraacetic acid). CTX: Cefotaxime; CEC: Cefotaxime + clavulanic acid; CAZ: Ceftazidime; CAC: Ceftazidime + clavulanic acid; CX: Cefoxitin.
Figure 2 Department wise distribution distribution of patients with Klebsiella isolates.
ENT: Ear, nose, and throat.
Figure 3 Antimicrobial susceptibility pattern of Klebsiella isolates (n = 130).
- Citation: Kaur H, Arora S, Sharma V, Kaur K, Kamboj S. Study of extended-spectrum beta-lactamases and AmpC beta-lactamases producing Klebsiella from clinical samples in tertiary care hospital of Punjab. World J Virol 2026; 15(1): 118602
- URL: https://www.wjgnet.com/2220-3249/full/v15/i1/118602.htm
- DOI: https://dx.doi.org/10.5501/wjv.v15.i1.118602